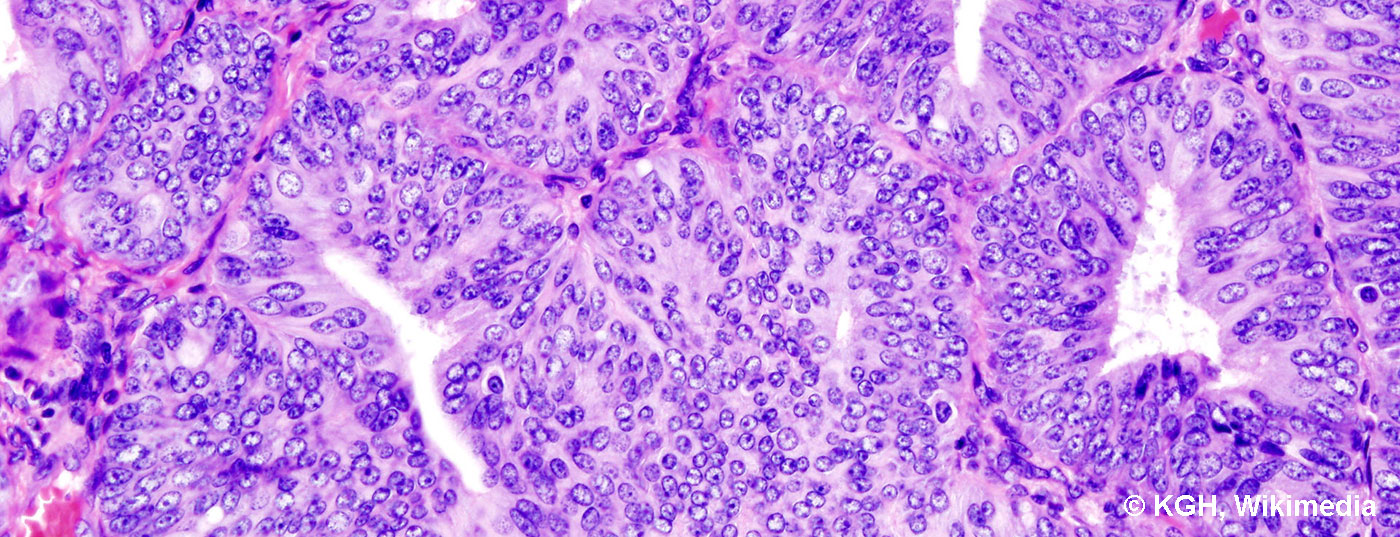

Il n’existe pas de dépistage établi pour les cancers de l’endomètre et des ovaires. Par conséquent, toute femme présentant des saignements postménopausiques ou atypiques préménopausiques doit être examinée et, le cas échéant, faire l’objet d’un examen complémentaire. Le cancer précoce de l’ovaire est souvent découvert par hasard. Seul le cancer du col de l’utérus peut être dépisté efficacement par frottis cervico-utérin.
Alors que le cancer du sein est le cancer le plus fréquent chez la femme en Suisse, avec 32,5% de tous les nouveaux diagnostics de cancer, le cancer de l’endomètre se situe en cinquième position en termes d’incidence. Le cancer de l’ovaire, bien que légèrement moins fréquent, présente une mortalité plus élevée ou un moins bon pronostic. Le cancer du col de l’utérus, dont l’incidence a diminué au cours des deux dernières décennies grâce au dépistage de la dysplasie cervicale, n’arrive qu’en 15e position. Le carcinome de la vulve est encore plus rare, puisqu’il représente à peine 1% de tous les nouveaux diagnostics de cancer chez la femme [1].
Le cancer de l’endomètre [2–4]
Le cancer de l’endomètre est considéré comme un carcinome de la femme âgée. Toutefois, il apparaît également à un âge plus jeune, en particulier en présence de syndromes tumoraux familiaux tels que le cancer colique héréditaire non polyposique (HNPCC ou syndrome de Lynch). On distingue deux types de carcinome de l’endomètre. Le cancer de l’endomètre de type I correspond histologiquement au cancer de l’endomètre endométrioïde, qui est associé aux œstrogènes et plutôt bien différencié, et qui présente par conséquent un pronostic plus favorable. Le facteur de risque influençable pour ce carcinome est le syndrome métabolique, en particulier l’obésité et l’hypertension. Le cancer de l’endomètre de type II correspond généralement, sur le plan histologique, à un type séreux ou à cellules claires. Il n’est pas associé aux œstrogènes et est comparable au cancer de l’ovaire en termes de pronostic et de traitement à mettre en œuvre, c’est-à-dire qu’il est associé à un pronostic nettement moins favorable. Il n’existe pas de facteurs de risque typiques pour le carcinome de type II.
Le dépistage généralisé du cancer de l’endomètre ou de ses précurseurs par échographie transvaginale n’est pas recommandé chez la femme asymptomatique, car aucun bénéfice n’a été démontré à ce jour. Cela vaut également pour les femmes sous traitement au tamoxifène pour un cancer du sein. Toutefois, toute femme présentant des saignements post-ménopausiques ou des saignements atypiques en pré-ménopause doit être examinée par un gynécologue et par échographie transvaginale et faire l’objet d’un examen complémentaire si nécessaire. Il convient de noter que les cancers de type II, en particulier, ne présentent pas toujours l’image échographique typique d’un endomètre hautement développé et inhomogène (Fig. 1).

L’examen histologique, qui se fait généralement par hystéroscopie et curetage, est impératif, notamment en cas de saignements post-ménopause répétés et en présence de facteurs de risque tels que l’obésité, l’hypertension, le diabète sucré, mais aussi en cas de SOP (syndrome des ovaires polykystiques), de syndrome HNPCC ou de traitement au tamoxifène (fig. 2).

Une fois le diagnostic histologique établi, il est recommandé de procéder à un staging radiologique, par exemple par tomodensitométrie de l’abdomen et du thorax, avant de mettre en œuvre le traitement définitif. Le traitement du cancer de l’endomètre consiste en premier lieu en une hystérectomie avec annexectomie. Pour les cancers de type I bien ou modérément différenciés, sans infiltration myométriale étendue et avec des ganglions lymphatiques rétropéritonéaux normaux à l’imagerie, ce traitement chirurgical est généralement suffisant. En outre, une radiothérapie intravaginale doit être évaluée en postopératoire.
Dans le cas des carcinomes endométrioïdes G3 et de tous les carcinomes de type II, les directives actuelles indiquent, en plus de l’hystérectomie, une lymphonectomie pelvienne et para-aortique, ainsi qu’un débullage de la tumeur en cas d’atteinte péritonéale, par analogie avec le cancer de l’ovaire. En outre, dans la plupart des cas, une chimiothérapie (carboplatine et paclitaxel) et éventuellement une radiothérapie pelvienne percutanée sont recommandées dans le cadre du traitement postopératoire. La place de la lymphonectomie rétropéritonéale systématique est controversée et fait actuellement l’objet de plusieurs études. En particulier en combinaison avec une radiothérapie ultérieure, des lymphœdèmes des jambes peuvent apparaître chez jusqu’à 40% des patientes. Actuellement, on évalue si la lymphonectomie sentinelle pourrait avoir une place dans l’algorithme de traitement du cancer de l’endomètre.
Le suivi est d’une part axé sur les symptômes, mais il s’agit d’autre part de trouver le plus tôt possible la récidive centrale sur le moignon vaginal, car celle-ci peut continuer à être traitée dans une optique curative. C’est pourquoi des prélèvements cytologiques sont effectués tous les six mois à partir de la colpotomie, ainsi qu’une échographie transvaginale à chaque contrôle. Les intervalles de contrôle sont fixés tous les trois à quatre mois pendant les trois premières années après le traitement, puis tous les six mois. Des contrôles annuels peuvent être effectués à partir de cinq ans après le traitement. L’imagerie de routine, comme la tomodensitométrie ou l’IRM, ainsi que les contrôles de laboratoire ne sont pas recommandés et doivent être effectués en cas de symptômes spécifiques [5].
Le cancer de l’ovaire [6–8]
On distingue le cancer de l’ovaire précoce, limité aux annexes et à l’utérus (jusqu’au stade IIA de la FIGO), et le cancer de l’ovaire avancé, qui s’étend au niveau péritonéal et présente souvent une atteinte étendue du Douglas, de l’épiploon et des organes abdominaux supérieurs, y compris. diaphragme et la capsule hépatique. 10% des cancers de l’ovaire sont d’origine génétique, principalement en raison d’une mutation BRCA (“hereditary breast-ovarian cancer syndrome”). Le risque à vie de développer un cancer de l’ovaire en cas de mutation génétique avérée peut atteindre 60%.
En ce qui concerne le cancer de l’ovaire, il n’existe pas non plus à ce jour de preuves d’un dépistage efficace, en particulier chez les femmes dont la mutation BRCA est connue.
Le cancer précoce de l’ovaire est souvent une découverte fortuite dans le sens d’une anomalie inexpliquée de l’annexe avec des symptômes absents ou non spécifiques. En cas de cancer de l’ovaire avancé, des symptômes non spécifiques dus à la carcinose péritonéale apparaissent généralement – sensation de plénitude, augmentation du volume de l’abdomen, malaise, douleurs abdominales diffuses, etc.

Le traitement du cancer de l’ovaire consiste en une chirurgie suivie d’une chimiothérapie (généralement six cycles de carboplatine/Taxol®). Sur le plan chirurgical, l’hystérectomie comprend une annexectomie bilatérale, une omentectomie, des biopsies péritonéales ainsi qu’une lymphonodectomie pelvienne et paraaortique et, dans certains cas, une appendicectomie. En cas d’atteinte péritonéale, l’ablation la plus complète possible de toutes les zones touchées par la tumeur est associée à un meilleur pronostic qu’une chirurgie tumorale incomplète. Cela signifie que si l’état général le permet, il faut souvent procéder à une résection multiviscérale avec, par exemple, une résection rectosigmoïdienne, d’autres résections partielles de l’intestin, un stripping du diaphragme, une résection de la capsule hépatique et/ou une splénectomie. En conséquence, le setting chirurgical doit être planifié de manière interdisciplinaire avec des conditions anesthésiques et de soins intensifs adéquates. Si le diagnostic n’est toujours pas clair sur la base des examens ou si l’ablation chirurgicale complète n’est que douteusement possible, on procède en premier lieu à une laparoscopie diagnostique ou, le cas échéant, on commence directement la chimiothérapie. En cas de bonne réponse, le traitement chirurgical peut être effectué après trois cycles de chimiothérapie sous forme de débullage par intervalles. Si une résection complète n’a pas pu être réalisée au stade FIGO III, la chimiothérapie est associée au bevacizumab, suivi d’un traitement d’entretien.

Le suivi du cancer de l’ovaire est principalement axé sur les symptômes, avec les mêmes intervalles de contrôle que pour le cancer de l’endomètre. Lors de chaque contrôle, une échographie transvaginale est réalisée en plus de l’examen gynécologique et un frottis cytologique de la colpotomie est effectué une fois par an. La tomodensitométrie et les marqueurs tumoraux ne doivent être réalisés qu’en cas de symptômes et de suspicion de récidive, car la détection précoce de la récidive asymptomatique entraîne une moins bonne qualité de vie avec anticipation de la phase palliative et des effets secondaires du traitement sans incidence sur la survie globale.
Le cancer du col de l’utérus [9,10]
Pratiquement tous les cancers du col de l’utérus sont associés à l’HPV (Fig. 5), les types d’HPV 16 et 18 étant responsables de 70 à 80% de tous les cancers du col de l’utérus. Ces deux types sont couverts par la vaccination contre le HPV dans le cadre du programme national de vaccination depuis 2008. Le dépistage des lésions précancéreuses du col de l’utérus s’effectue au moyen de frottis cervicaux cytologiques annuels (frottis PAP) et est recommandé pour la première fois à 21 ans. Si les trois derniers frottis sont normaux et qu’il n’y a pas d’autres facteurs de risque, les intervalles peuvent être étendus à tous les deux ou trois ans. En outre, le dépistage de l’HPV est actuellement discuté à la place de l’examen cytologique [11].

Après le diagnostic histologique d’un cancer du col de l’utérus, une évaluation clinique et d’imagerie du stade de la tumeur est effectuée. Pour les cancers du col de l’utérus précoces jusqu’au stade Ib1 de la FIGO (taille de la tumeur <4 cm), le traitement chirurgical consiste généralement en une hystérectomie élargie et une lymphonodectomie pelvienne et para-aortique profonde, tandis que pour les stades plus avancés, la radiochimiothérapie combinée primaire est utilisée. Dans le cas du cancer du col de l’utérus, la place de la lymphonectomie sentinelle est également en cours d’évaluation.
Dans le cadre du suivi, il s’agit de détecter précocement la récidive centrale ou la récidive de la paroi pelvienne. Tous les contrôles doivent donc inclure un frottis cytologique de la colpotomie, une échographie transvaginale et une échographie du pelvis rénal.
Messages Take-Home
- Il n’existe pas de dépistage établi et efficace pour les cancers de l’endomètre et des ovaires.
- Pratiquement tous les cancers du col de l’utérus sont associés à l’HPV. Pour le cancer du col de l’utérus, il existe un dépistage efficace grâce aux frottis cervicaux cytologiques (PAP). A l’avenir, cela se fera probablement par le biais du dépistage de l’HPV.
- Toute femme souffrant de saignements postménopausiques ou de saignements atypiques en préménopause doit être suivie par un gynécologue et par un examen transvaginal.
- Il est également possible de procéder à une hystéroscopie et à un curetage.
- Le traitement chirurgical du cancer de l’ovaire avancé nécessite une équipe interdisciplinaire bien rodée. Le soin apporté
- la planification pré-thérapeutique et la discussion interdisciplinaire du concept thérapeutique sont essentielles pour le résultat.
Littérature :
- Office fédéral de la statistique (OFS), Institut national d’épidémiologie et d’enregistrement du cancer (NICER) : Le cancer en Suisse, état et évolution de 1983 à 2007.
- Emons G, et al. : Version de consultation. Rapport sur les lignes directrices. S3-Leitlinie Diagnostic, traitement et suivi des patientes atteintes d’un cancer de l’endomètre. Numéro de registre AWMF 032/034OL. 2017.
- Colombo N, et al : Endometrial cancer : ESMO Clinical Practice Guidelines for diagnosis, treatment and follow-up. Ann Oncol 2013 ; 24(Suppl 6) : vi33-8.
- Lignes directrices du NCCN : Néoplasmes utérins. 2017.
- Groupe de travail d’oncologie gynécologique de la SSGO : Recommandations de suivi oncologique gynécologique. 2009.
- DGGG : Ligne directrice S3 Diagnostic, traitement et suivi des tumeurs malignes de l’ovaire. Numéro de registre AWMF 032/035OL. 2017.
- Ledermann JA, et al : Carcinome épithélial de l’ovaire nouvellement diagnostiqué et en rechute : Lignes directrices de pratique clinique de l’ESMO pour le diagnostic, le traitement et le suivi. Ann Oncol 2013 ; 24(Suppl 6) : vi24-32.
- Lignes directrices du NCCN : Cancer de l’ovaire. 2017.
- DGGG, AGO : S3-Leitlinie Diagnostic, traitement et suivi des patientes atteintes d’un cancer du col de l’utérus. Numéro de registre AWMF 032/033OL. 2014.
- Lignes directrices du NCCN : Cancer du col de l’utérus. 2017.
- Gerber S, et al. : Mise à jour du dépistage du cancer du col de l’utérus et suivi par colposcopie. Lettre aux experts de la SSGO No 40. 2012.
InFo ONKOLOGIE & HÉMATOLOGIE 2018 ; 6(1) : 6-10